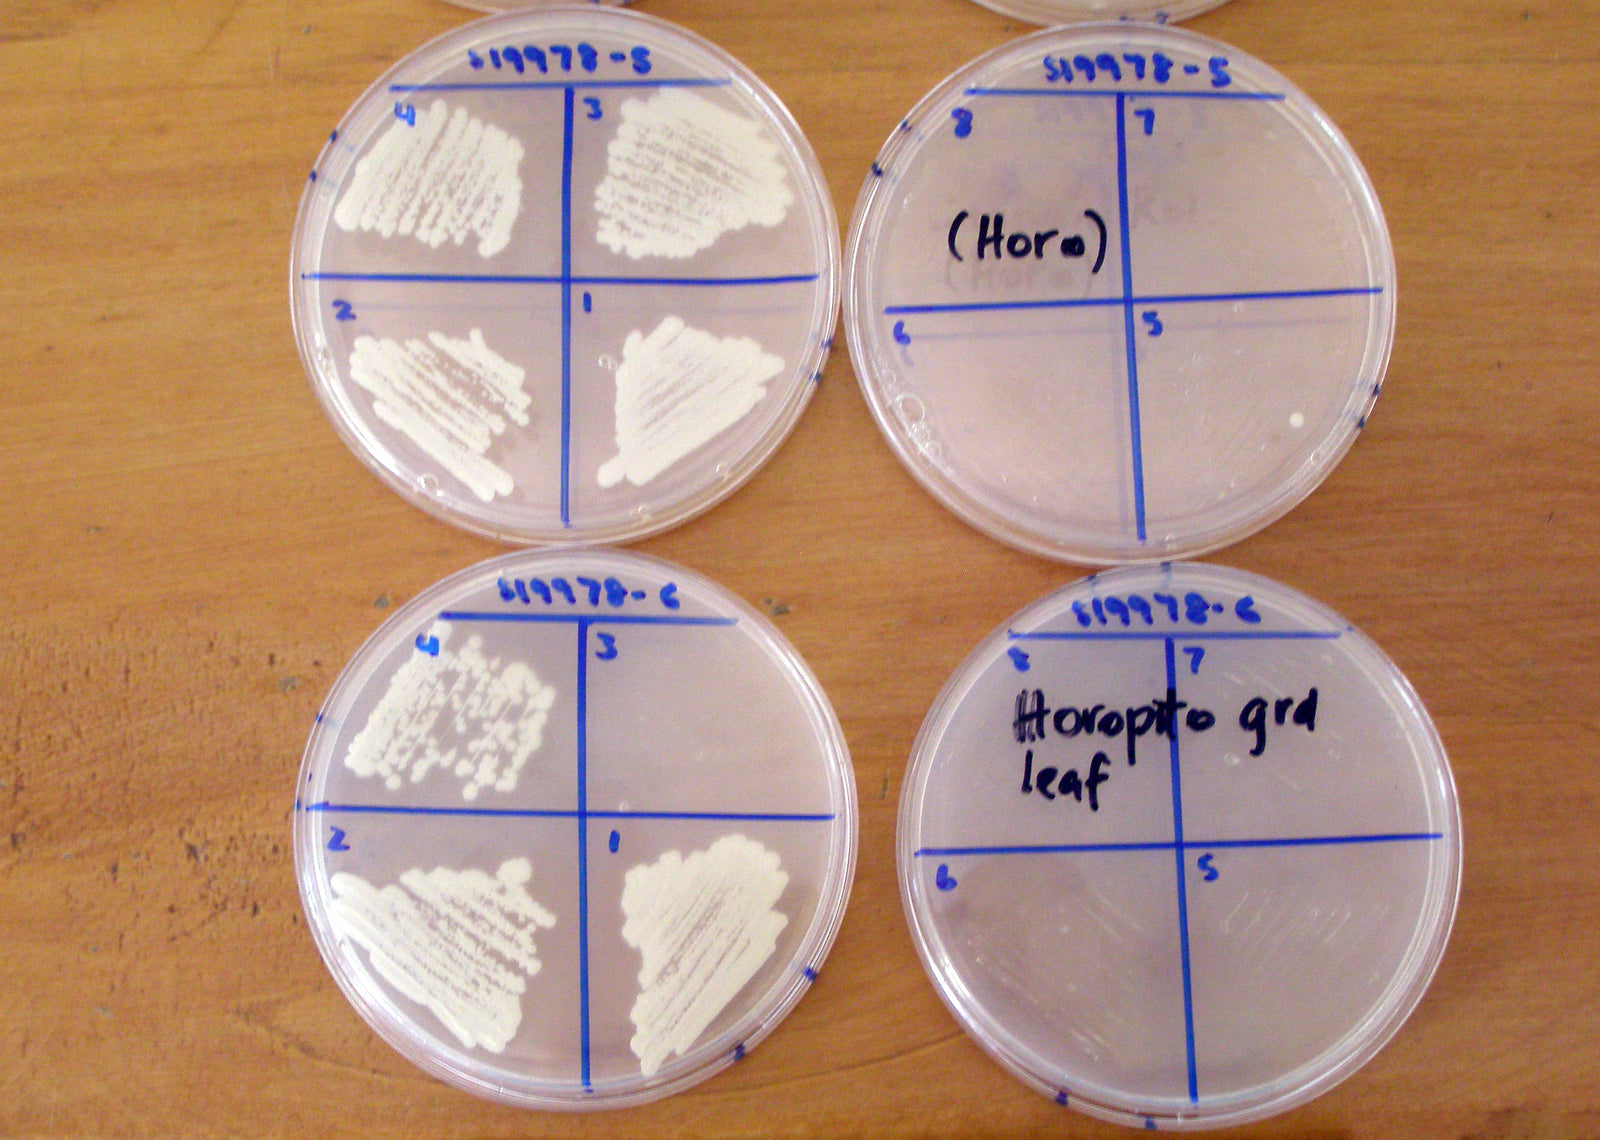

Forest Herbs Research
The story begins with research into the bio-active properties of an indigenous herb. Horopito, Pseudowintera colorata, is a 65-million-year old-herb, endemic to New Zealand. It is commonly known as pepper tree and is an ancient & medicinal shrub used in Rongoā, a traditional Māori healing system.
Horopito has intelligently adapted to thrive in the damp, dark conditions of the rainforest by building up natural chemical defenses to protect against attacking pathogens and microbes e.g. fungi. The active compound, polygodial, is extracted for Kolorex products.
Peter Butler, the founder of Forest Herbs Research Ltd, has dedicated his life to studying and growing Horopito in Golden Bay, New Zealand.
Nature and Science
Almost 30 years of R&D has gone into sustainably growing a potent form of Horopito and learning how to extract its bio-active compound Polygodial. We transform nature's wisdom into the Kolorex women and men's intimate care collection, derma range and gut care products.
The Kolorex collection adheres to the highest standards of what is truly natural. The product range contains no parabens, mineral oils, synthetic preservatives, synthetic fragrances or SLS/SLES. Instead, Kolorex uses a natural Vitamin E preservative system.
We like to keep things clean and simple. It's in our nature.

our eco warrior
horopito's bio-acivity
The red leaf colouration is a bio-active compound called 'Polygodial'.
The red Polygodial has been sent by the plant to where it's being attacked by pathogens, fungi or insects. (see the insect holes in the leaf).
Polygodial works by breaking down the cell walls of pathogens and microbes, quickly rendering the cells fatally damaged.






